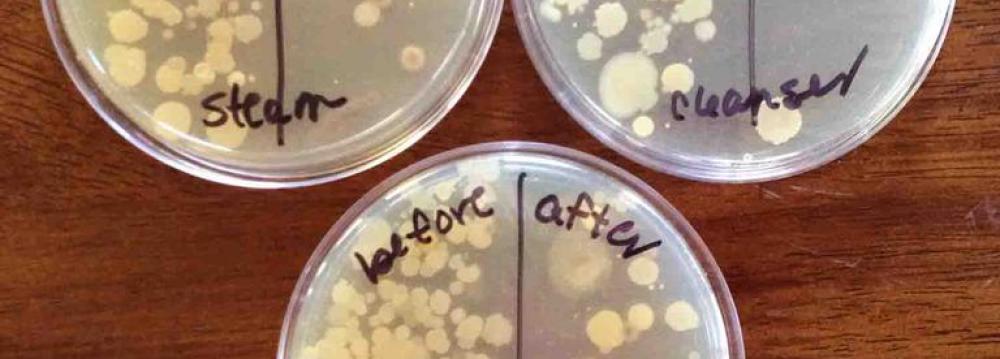

Mother’s milk, which consists of a complex and continually changing blend of proteins, fats and sugars, helps protect babies against bacterial infections.
In the past, scientists have concentrated their search for the source of its antibacterial properties on the proteins it contains. However, an interdisciplinary team of chemists and doctors at Vanderbilt University have discovered that some of the carbohydrates in human milk not only possess antibacterial properties of their own but also enhance the effectiveness of the antibacterial proteins also present, news-medical.net reported.
“This is the first example of generalized, antimicrobial activity on the part of the carbohydrates in human milk,” said assistant professor of chemistry, Steven Townsend, who directed the study. “One of the remarkable properties of these compounds is that they are clearly non-toxic, unlike most antibiotics.”
The results were presented Aug. 20 at the annual meeting of the American Chemical Society in Washington DC by doctoral student Dorothy Ackerman and published in the ACS Infectious Diseases journal.
The basic motivation for the research was the growing problem of bacterial resistance to antibiotics, which kills tens of thousands every year.
“We started to look for different methods to defeat infectious bacteria. For inspiration, we turned to one particular bacteria, Group B Strep. We wondered whether its common host, pregnant women, produces compounds that can either weaken or kill strep, which is a leading cause of infections in newborns worldwide,” Townsend said.
Instead of searching for proteins in human milk with antimicrobial properties, Townsend and his colleagues turned their attention to the sugars, which are considerably more difficult to study.
Interesting Results
To do so, the researchers collected human milk carbohydrates, also called oligosaccharides, from a number of different donor samples and profiled them with a mass spectrometry technique that can identify thousands of large biomolecules simultaneously. Then they added the compounds to strep cultures and observed the result under the microscope. This showed that not only do some of these oligosaccharides kill the bacteria directly but some also physically break down the biofilms that the bacteria form to protect themselves.
In a pilot study, Townsend’s lab collected five samples. They found that the sugars from one sample nearly killed an entire strep colony. In another sample, the sugars were moderately effective while the remaining three samples exhibited a lower level of activity. In a follow-up study, they are testing more than two dozen additional samples. So far, two broke down the bacterial biofilms and killed the bacteria, four broke down the biofilms but did not kill the bacteria and two killed the bacteria without breaking down the biofilms.
“Our results show that these sugars have a one-two punch,” said Townsend. “First, they sensitize the target bacteria and then they kill them. Biologist sometimes call this ‘synthetic lethality’ and there is a major push to develop new antimicrobial drugs with this capability.”
By dosing strep cultures with a mixture of milk sugars and antimicrobial peptides from human saliva, the researchers also showed that the sugars’ ability to break down biofilms can also enhance the effectiveness of the other antimicrobial agents that breast milk contains.